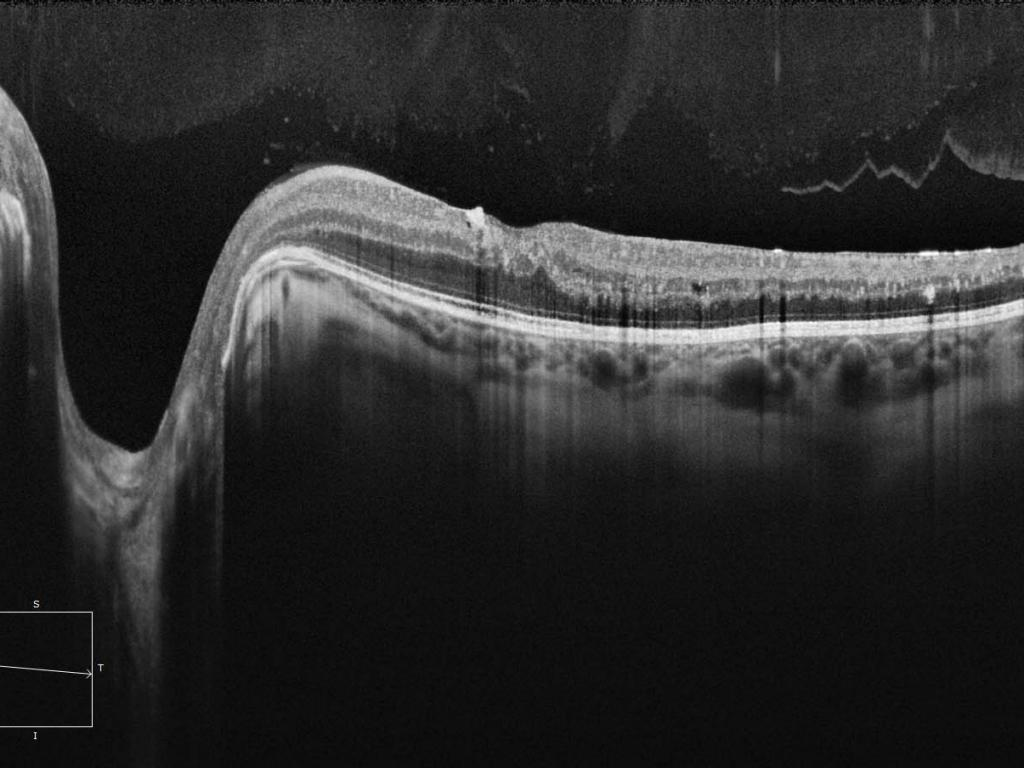

Thank you for contacting us!
Thank you for contacting us!
We've received your inquiry.
Due to high demand, our respons time may take 1-2 business days.
We appreciate your patience and understanding.
 Thank you for contacting us!
Thank you for contacting us!
We've received your inquiry.
Due to high demand, our respons time may take 1-2 business days.
We appreciate your patience and understanding.
Bgn admin
2026.02.23At BGN Eye Clinic, every patient goes through a structured, safe, and fully guided journey from the first examination to post-surgery care.
Here’s a simple summary of each step.
STEP 1 — Comprehensive Eye Examination
We begin with a full diagnostic exam using premium ZEISS technology.
Your cornea shape, cornea thickness, retina, optic nerve, dryness level, and overall eye health are scanned in detail.
This step takes about 2–3 hours and builds the foundation for your customized treatment plan.

STEP 2 — Detailed Consultation & Q&A
The doctor reviews all your results clearly and explains what they mean.
You can ask anything — recovery, pain, travel, daily life, and surgery expectations.
The goal is to make sure you feel informed and confident.
STEP 3 — Choosing the Right Surgery
Based on your scans, the doctor recommends the safest and most accurate procedure:
• SMILE Pro
• SMILE LASIK
• LASEK
• ICL
You’ll understand why this method fits your eyes and what results to expect.
STEP 4 — Preparation for Surgery
Before entering the laser room:
• Final measurements are checked
• Gentle numbing drops are applied
• The eye area is cleaned for safety
• The team makes sure you’re relaxed and ready
No needles, no injections — only comfortable eye drops.
STEP 5 — 10-Minute Surgery
You lie comfortably on the laser bed.
The doctor guides you to follow a small light — no pain, just mild pressure.
The entire procedure takes around 10 minutes, with only seconds of laser time per eye.
Most patients say, “It was faster than expected!

STEP 6 — Immediate Post-Op Care
After surgery, the team checks your vision, applies protective drops, and explains all after-care instructions.
You rest briefly, and most patients go home the same day.
STEP 7 — Recovery & Follow-Up
The next day, you return for a check-up.
Vision improves quickly, especially after SMILE Pro.
The clinic continues to monitor your healing to ensure perfect, safe recovery.
